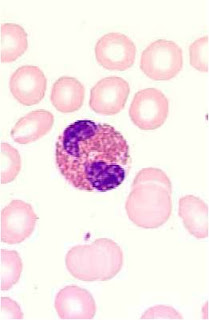

Esta página es un apoyo más para los laboratoristas clínicos que estudian las alteraciones de la sangre, no solo leucemias, sino también anemias, coagulopatías, técnicas, manuales y parámetros de evaluación para la materia de "Aplicar tecnicas de valoración hemostatica y detección de leucemias"
BIENVENIDOS ALUMNOS DE LABORATORIO CLÍNICO TURNO VESPERTINO
ESTA PÁGINA ESTÁ A TU SERVICIO, EN ELLA ENCONTRARÁS TODA LA INFORMACIÓN MÁS RELEVANTE DEL CURSO, COMO EL PROGRAMA, LISTAS DE COTEJO, RÚBRICAS DE LAS PRÁCTICAS E INFORMACIÓN SOBRE FECHAS DE EXÁMENES, ENTREGA DE REPORTES Y MATERIAL DE APOYO PARA QUE EL CURSO SEA MÁS SENCILLO
domingo, 19 de septiembre de 2010
VALORES DE REFERENCIA PARA LA CITOMETRÍA HEMÁTICA
LES PROPORCIONO LA INFORMACIÓN DE LA MATERIA EN RELACION CON LA FÓRMULA ROJA.
IMPRIMIRLA DE PREFERENCIA A COLOR PARA USARLA EN LAS PRÁCTICAS.
VISITA LA PÁGINA: http://www.journals.unam.mx/index.php/rfm/article/viewFile/19066/18093
EN ESTA PÁGINA ENCONTRARAS VALORES ACUTALIZADOS ASÍ COMO IMÁGENES DE LAS PRINCIPALES POIQUILOCITOSIS Y ANISOCITOSIS.
viernes, 20 de agosto de 2010
HOJA DE COTEJO PARA EL TRABAJO DE LABORATORIO
Hoja de cotejo para el trabajo en las prácticas de
LEUCEMIAS Y HEMOSTASIA
Nombre _________________________________________ Grupo ___
Materia _______________ Práctica___________
| | Criterio | ||
| Indicador | Excelente 3 pts | Bueno 2 pts | Regular 1 pto |
| 1.-Llega puntual a la hora de la clase | | | |
| 2.- PRESENTA BATA DE LABORATORIO | | | |
| 3.- Presenta guantes | | | |
| 4.- Ubica la práctica de la sesión en su manual | | | |
| 5.- Solicita el material de laboratorio mediante el Vale correspondiente | | | |
| 6.- Trabaja en orden y con limpieza | | | |
| 7.- Aclara sus dudas antes de realizar un procedimiento | | | |
| 8.- Emplea adecuadamente el espectrofotómetro | | | |
| 9.- Su medición y cálculos son coherentes con la muestra | | | |
| 10.- Entrega su material limpio y en buen Estado | | | |
| 11.- Deja la mesa y lugar de trabajo limpio y y yordenado | | | |
| Suma total | | | |
| Calificación obtenida (Asignada por el profesor) | |
| Calificación obtenida (Autoevaluación) | |
| Calificación obtenida (Equipo de trabajo) | |
| Promedio final | |
domingo, 15 de agosto de 2010
EL DIAGNOSTICO DE PATOLOGÍAS DE LA SERIE BLANCA
El propósito de este curso es dar a conocer
las características morfológicas celulares y clínicas de
diversas patologías como lo son aquellas que afectan las células de la sangre
las características morfológicas celulares y clínicas de
diversas patologías como lo son aquellas que afectan las células de la sangre
, dentro de la cual podemos mencionar las
multilobulaciones del núcleo de neutrofilos; Enfermedades
hereditarias como la de Béquez-Chediak-Higashi , Enfermedades
infecciosas causadas por piógenos que producen alteraciones en la
estructura de las células y Enfermedades metabólicas hereditarias
como la leucemía y hemofilia, por mencionar solo algunas.
El conocimiento de este campo, es de suma importancia
para el laboratorista clínicoya que, el saber cada una de las características
multilobulaciones del núcleo de neutrofilos; Enfermedades
hereditarias como la de Béquez-Chediak-Higashi , Enfermedades
infecciosas causadas por piógenos que producen alteraciones en la
estructura de las células y Enfermedades metabólicas hereditarias
como la leucemía y hemofilia, por mencionar solo algunas.
El conocimiento de este campo, es de suma importancia
para el laboratorista clínicoya que, el saber cada una de las características
que diferencian una enfermedad o alteración de otra es fundamental para el
diagnóstico de la misma, y por tanto, colaborar con el médico
para poder proporcionarle un tratamiento adecuado a nuestro
paciente.
Actualmente se sabe que, se han hecho investigaciones
acerca de las leucemias y las coagulopatíasy otros tipos de
trastornos de la sangre que requieren el cuidado clínico de un
médico u otro profesional de la salud.
diagnóstico de la misma, y por tanto, colaborar con el médico
para poder proporcionarle un tratamiento adecuado a nuestro
paciente.
Actualmente se sabe que, se han hecho investigaciones
acerca de las leucemias y las coagulopatíasy otros tipos de
trastornos de la sangre que requieren el cuidado clínico de un
médico u otro profesional de la salud.
Suscribirse a:
Comentarios (Atom)